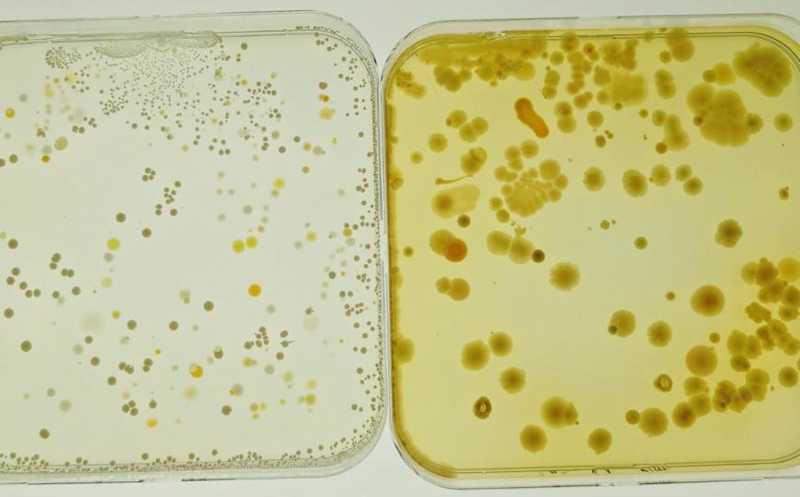

Листерии защитились от антисептика, образуя биопленки с другими видами бактерий
Источником бактерий Listeria monocytogenes, вызывающих листериоз, могут быть фрукты и их упаковка. Антисептическая обработка производственных помещений не всегда помогает, и ученые из Пенсильвании выяснили почему. Оказалось, что бактерии, относящиеся к семействам Pseudomonadaceae и Xanthomonadaceae, образуют биопленки, которые защищают листерий от воздействия антисептиков. В частности, они сделали листерию устойчивой к хлориду бензалкония, распространенному дезинфицирующему средству.
Микробиота с упаковки фруктов, выращенная в лаборатории
Credit:
Penn State | Пресс-релиз
Листериоз — потенциально смертельное инфекционное заболевание, вызываемое бактериями Listeria monocytogenes. Зачастую источником листерий становятся фрукты и упаковка, в которой они продаются. Ученые из Университета штата Пенсильвания показали, что на предприятиях пищевой промышленности бактерии L. monocytogenes могут выживать даже после обработки противомикробными средствами за счет образования биопленок, включающих бактерии разных семейств. В частности, совместное культивирование с бактериями семейств Pseudomonadaceae и Xanthomonadaceae способствовало повышению устойчивости листерий к воздействию хлорида бензалкония (BAC).
Ученые собрали образцы микробиоты окружающей среды с поверхностей, не контактирующих с пищевыми продуктами, на трех предприятиях по упаковке фруктов в США. Затем с помощью ПЦР амплифицировали гены бактериальных 16S рРНК и провели секвенирование. Используя систему Prospector для культивирования и изоляции бактерий, авторы работы идентифицировали 248 изолятов, относящиеся к четырем семействам: Enterobacteriaceae, Erwiniaceae, Microbacteriaceae и Pseudomonadaceae. Культивирование образцов на агаре R2A позволило выявить еще более двух десятков семейств бактерий, включая Xanthomonadaceae и Flavobacteriaceae.
Затем ученые оценили минимальную ингибирующую концентрацию (МИК) BAC и обнаружили, что этот показатель различался для разных семейств бактерий. Так, для большинства штаммов L. monocytogenes МИК составила 1,56 ppm, только у одного из штаммов 3,12 ppm, еще у одного 6,25 ppm. Для бактерий семейств Flavobacteriaceae, Microbacteriaceae, Xanthomonadaceae и Pseudomonadaceae минимальная ингибирующая концентрация BAC была выше, чем у листерий, и доходила до 100 ppm у некоторых штаммов Pseudomonadaceae.
Биоинформатический анализ только у одного штамма L. monocytogenes выявил ген, ассоциированный с устойчивостью к BAC, — qacC. Ген emrE, также придающий устойчивость к BAC, был обнаружен у Flavobacteriaceae и Xanthomonadaceae; ген qacA — у некоторых штаммов Microbacteriaceae, Pseudomonadaceae и Xanthomonadaceae; ген множественной лекарственной устойчивости mexAB — у Pseudomonadaceae и Xanthomonadaceae, а ген cnt, продукт которого участвует в расщеплении четвертичных аммонийных соединений, к которым относится BAC, — у Microbacteriaceae и Pseudomonadaceae.
Выращивание биопленок в лабораторных условиях показало, что колонии, содержащие только L. monocytogenes, образуют меньшее количество биопленок, чем колонии Pseudomonadaceae, Xanthomonadaceae и Microbacteriaceae, при этом больше всего биопленок образовывали Pseudomonadaceae. Совместное культивирование L. monocytogenes с Pseudomonadaceae и (или) Xanthomonadaceae способствовало образованию большего объема биопленок и бактериальной биомассы. Наиболее активно L. monocytogenes росли в средах с высоким видовым разнообразием.
Конфокальная лазерная сканирующая микроскопия (CLSM) показала, что биопленки, образованные бактериями одного семейства или вида, относящимися к Microbacteriaceae, Flavobacteriaceae или L. monocytogenes, не покрывали поверхность сплошным слоем, а формировали микроколонии. Чем больше было видовое разнообразие колонии, тем более непрерывным становилось покрытие биопленкой поверхности. Бактерии семейств Pseudomonadaceae и Xanthomonadaceae, напротив, показали высокую способность к образованию биопленок, не зависимую от разнообразия.
Полногеномное секвенирование позволило выявить гены, связанные с производством компонентов бактериального внеклеточного матрикса. В частности, во всех изолятах Flavobacteriaceae и Pseudomonadaceae, двух изолятах Microbacteriaceae и семи изолятах Xanthomonadaceae присутствовали гены algD или algU, связанные с синтезом альгината. Обнаруживались и другие гены, ассоциированные с синтезом полисахаридов, такие как rnlA, peb, pelF и pelD, а также у Pseudomonadaceae были найдены гены, связанные с высвобождением внеклеточной ДНК.
Наконец, исследователи обнаружили, что биопленки, образуемые при совместном культивировании L. monocytogenes с Pseudomonadaceae, Microbacteriaceae или Xanthomonadaceae повышали устойчивость листерий к воздействию BAC. Для этого культуры обрабатывали BAC в концентрации, в два раза превышающей МИК для листерий (12,5 ppm). Во всех планктонных культурах (то есть не образующих биопленки), включая монокультуры L. monocytogenes и совместные культуры с представителями других семейств, через 30 минут воздействия BAC значительно снижалась численность листерий. Напротив, в биопленках, образованных L. monocytogenes с Pseudomonadaceae, Microbacteriaceae или Xanthomonadaceae, биомасса листерий практически не изменялась даже спустя 2 часа воздействия BAC.
Таким образом, устойчивость листерий к антисептику значительно увеличивается, когда они образуют биопленку совместно с представителями других семейств. Эти данные помогут оптимизировать протоколы антисептической обработки производственных помещений пищевой промышленности.
Источник
Rolon M. L. et al. Multi-species biofilms of environmental microbiota isolated from fruit packing facilities promoted tolerance of Listeria monocytogenes to benzalkonium chloride // Biofilm, Volume 7, June 2024, DOI: 10.1016/j.bioflm.2024.100177


 Меню
Меню





 Все темы
Все темы




 0
0











